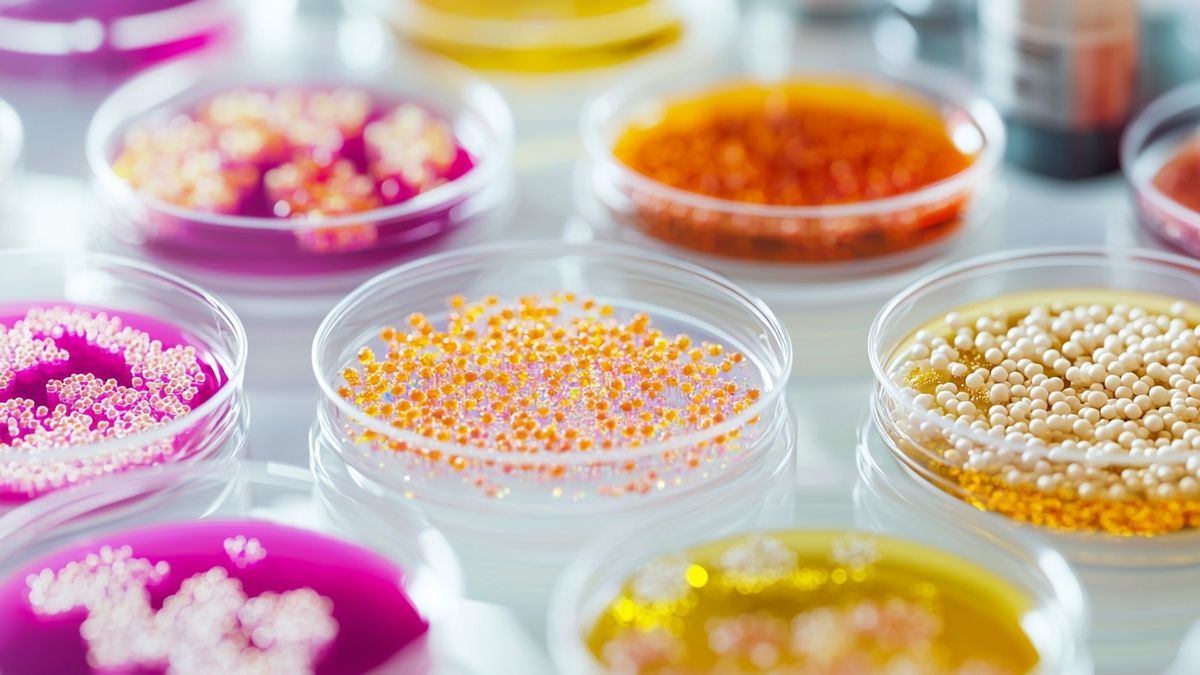
Cultures cellulaires et protéines alternatives pour une nutrition sportive

Les patchs cutanés révolutionnent la façon dont les athlètes surveillent leur santé. Grâce à des technologies microfluidiques avancées, ces dispositifs offrent une analyse de la[…]

Les implants temporaires jouent un rôle innovant dans la médecine du sport. Ils améliorent la récupération des athlètes tout en permettant un suivi précis de[…]

Les lentilles connectées émergent comme une solution innovante pour la surveillance du glucose chez les athlètes. Équipées de capteurs avancés, elles mesurent la glycémie via[…]
Les cultures cellulaires émergent comme une révolution dans la nutrition sportive. En offrant des protéines alternatives, elles répondent à la demande croissante de solutions durables[…]

Les aliments fonctionnels jouent un rôle clé dans l’optimisation des performances athlétiques. Ces « alicaments » ne se contentent pas de nourrir, ils contribuent également à la[…]

L’intelligence artificielle révolutionne la nutrition sportive en offrant des recommandations personnalisées basées sur des données précises. Des technologies innovantes permettent d’analyser les besoins nutritionnels des[…]

La spectroscopie proche infrarouge (NIRS) révolutionne l’analyse nutritionnelle et l’évaluation de la composition corporelle dans le domaine du sport. En offrant des mesures précises et[…]

Les capteurs biologiques révolutionnent le suivi des performances athlétiques. Grâce aux technologies de monitoring continu, les sportifs peuvent désormais recevoir des données précises en temps[…]

Les biosenseurs représentent une avancée formidable dans le suivi des performances des athlètes. Ces dispositifs, non invasifs, offrent un aperçu inestimable des métabolites clés influençant[…]

La pharmacogénomique révolutionne le monde du sport en offrant une compréhension fine de l’interaction entre génétique, nutrition et performance. Cette discipline permet aux athlètes de[…]